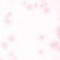

吉祥

爱德文(卢西奥)

曼达加百列

琥珀

白莲花精灵楚枰

千韩

夏安安

淑馨

伊瞳

库库鲁

黛薇薇

紫苏

若卿朽(作者)

安德鲁

撞羽

朝颜

其他人

塔巴斯

西蒙

灵国国王

靡

梅里美

安娜托利亚

雅加

普普拉

露娜

露莎

露露

夏木

莉莉

椿

小华
另一个

穷奇

白泽

齐格飞

夜华

梦霜

岚

爱德文

睡莲花精灵初萍

雅辛托斯

谛听

雪仙子

冰仙子

水系魔法师维章

模娅

莫娅

芬妮

紫罗兰精灵小棋

药店长洛明

甜品屋店长幽彩

燃香

画戟

安格斯

赛缪尔

北冥生

贝鲁多国王

贝鲁多王后

瑞雅

异国王子

可爱版曼达

医疗花仙琳恩

穆回

九千岁

满天星精灵王仁浠

亚伯

更天

北冥氏神幽吟

星辉圣神慕陵

黑暗魔神

洛

依

莹

华苏·卡塔尔娜